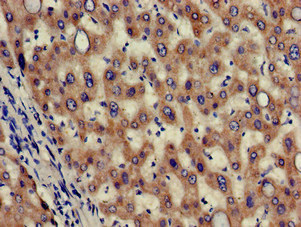
Immunohistochemistry of paraffin-embedded human liver tissue using CSB-PA882145LA01HU at dilution of 1:100 Immunohistochemistry of paraffin-embedded human liver tissue using CSB-PA882145LA01HU at dilution of 1:100

Western Blot Positive WB detected in: MCF-7 whole cell lysate, Rat kidney tissue, Mouse kidney tissue All lanes: HAO2 antibody at 3ug/ml Secondary Goat polyclonal to rabbit IgG at 1/50000 dilution Predicted band size: 39, 41 kDa Observed band size: 39 kDa
HAO2 Antibody
CSB-PA882145LA01HU
ApplicationsWestern Blot, ELISA, ImmunoHistoChemistry
Product group Antibodies
ReactivityHuman, Mouse, Rat
TargetHAO2
Overview
- SupplierCusabio
- Product NameHAO2 Antibody
- Delivery Days Customer20
- ApplicationsWestern Blot, ELISA, ImmunoHistoChemistry
- CertificationResearch Use Only
- ClonalityPolyclonal
- ConjugateUnconjugated
- Gene ID51179
- Target nameHAO2
- Target descriptionhydroxyacid oxidase 2
- Target synonymsGIG16, HAOX2, 2-Hydroxyacid oxidase 2, (S)-2-hydroxy-acid oxidase, peroxisomal, cell growth-inhibiting gene 16 protein, glycolate oxidase, hydroxyacid oxidase 2 (long chain), long chain alpha-hydroxy acid oxidase, long-chain L-2-hydroxy acid oxidase
- HostRabbit
- IsotypeIgG
- Protein IDQ9NYQ3
- Protein Name2-Hydroxyacid oxidase 2
- Scientific DescriptionCatalyzes the oxidation of L-alpha-hydroxy acids as well as, more slowly, that of L-alpha-amino acids.
- ReactivityHuman, Mouse, Rat
- Storage Instruction-20°C or -80°C
- UNSPSC41116161

![Lane 1: Marker [kDa] 250, 130, 95, 72, 55, 36, 28, 17, 10 | Lane 2: RT4 | Lane 3: U-251 MG | Lane 4: Human Plasma | Lane 5: Liver | Lane 6: Tonsil](https://atlasantibodies.s3.amazonaws.com/images/wb/hpa050355-wb-1.jpg)
